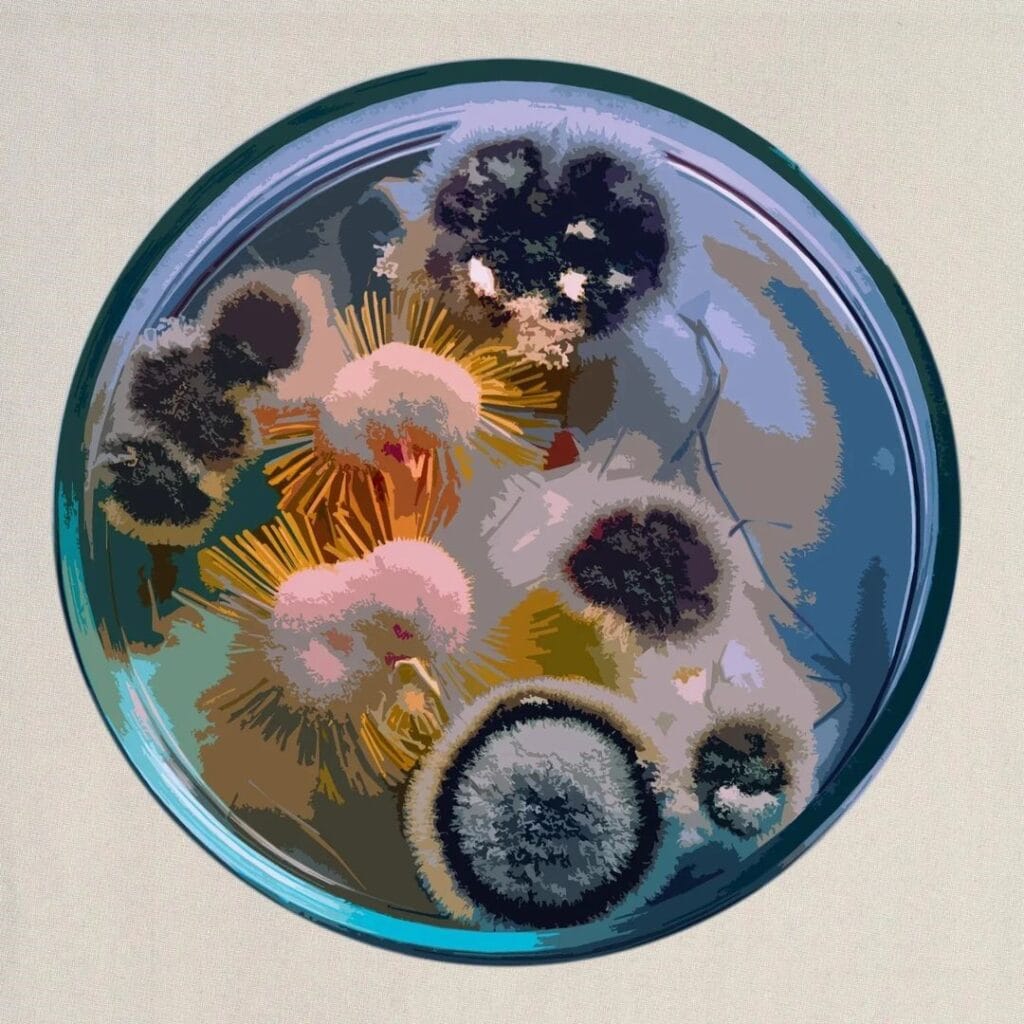

TÜRKÇE ROCK
Ankara’lı alternatif müzik grubu Kayıtsız yeni EP’si ‘Derinlerin Sahibi’ yayında

Ankara çıkışlı alternatif müzik grubu Kayıtsız, yeni EP çalışması “Derinlerin Sahibi” müzikseverlerle buluşturdu.
Yeni EP’si Derinlerin Sahibi’nin lansmanı için 14 Eylül Cumartesi gecesi saat 20.00’da Kadıköy The Wall sahnesinde!
1- Derinlerin Sahibi
2- Gökleri Keşfetmiş
3- minikgölgemᐸ3
4- Düş Peşimden
About The Author
Continue Reading






